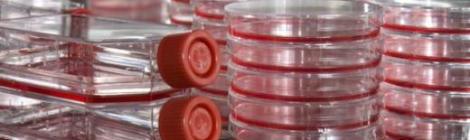

El verdadero precio de operarse de la vista con láser y las lentes intraoculares
La publicación on line El Confidencial ofrece un reportaje sobre los daños en la visión que pueden provocar las intervenciones quirúrgicas con láser. Lo hace bajo el título de Agujas […]